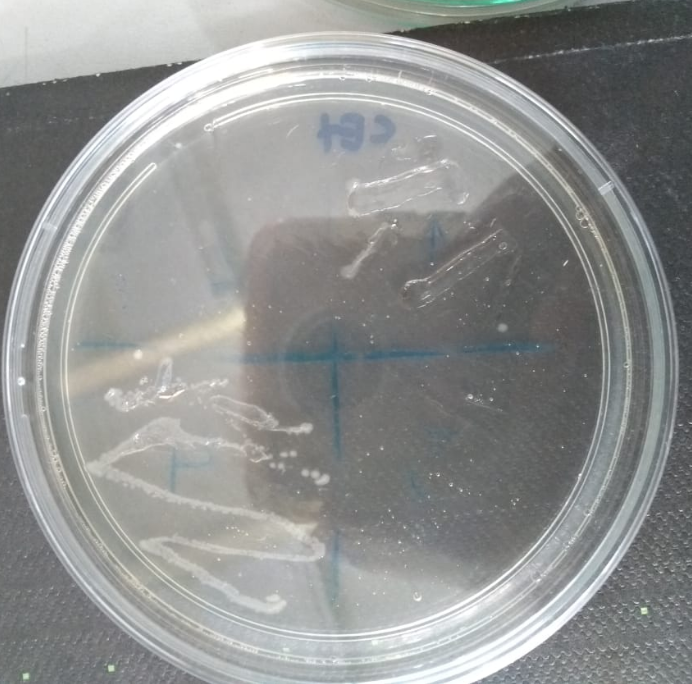

Agar Cetrimida Positivo
Www Condalab Com Int En Index Php Controller Attachment Id Attachment

Infoleg Ministerio De Justicia Y Derechos Humanos Argentina

Microbiologia Meios De Cultura E Provas De Identificacao

09 25 95 Norma Oficial Mexicana Nom 0 Ssa1 1994 Bienes Y Servicios
Http Www Ucv Ve Fileadmin User Upload Facultad Farmacia Catedramicro Cetrimida Pdf

Macconkey Agar Wikipedia
El agar cetrimida o cetrimide es un medio de cultivo sólido selectivo, diseñado para el aislamiento de Pseudomonas aeruginosa Está basado en poner en evidencia la producción de pigmentos característicos de esta especie y fue elaborado a partir de la modificación del agar Tech, creado por King, Ward y Raney.

Agar cetrimida positivo. Lowburry (8) is a modification of Tech Agar (Medium A) with addition of 01% cetrimide for selective isolation of Paeruginosa Later, due to the availability of the highly purified cetrimide, its concentration in the medium was decreased (9) The incubation was carried out at 37°C for a period of 14 hours (2). Media Format Pancreatic digest of Gelatin g/L, Magnesium Chloride 14g/L, Potassium Sulfate 10g/L, Cetrimide (Tetradecyltrimethylammonium Bromide) 03g/L, Agar 136g/L. Pasa esta prueba, se sembrarán los tubos positivos en agar Cetrimida y se incuba a 37 ºC durante 48 horas Éste también proporcionará nutrientes, estimuladores de la producción de piocianina (MgCl 2 y K 2 SO 4) y Cetrimida que, ademas de estimular la producción de fluoresceína, inhibe la flora acopañante de Pseudomonas (destruyendo las.
Agar cetrimida agar selectivo para Pseudomonas (base) para microbiología (According harm EP/USP/JP) Find MSDS or SDS, a COA, data sheets and more information. Agar cetrimida agar selectivo para Pseudomonas (base) para microbiología (According harm EP/USP/JP) Find MSDS or SDS, a COA, data sheets and more information. Cetrimida Agar Uso Medio utilizado para el aislamiento selectivo de Pseudomonas aeru ginosa y de otras especies del género Su fórmula cumple con los requerimientos de la Armonización de Farmacopeas Europea, Japonesa y de los Estados Unidos de Nor teamérica (EP, JP y USP respectivamente).
BD Pseudosel Agar Fórmula* por Litro de Água Purificada Hidrolisado pancreático de gelatina ,0 g Cloreto de magnésio 1,4 Sulfato de potássio 10,0 Glicerol 10,0 mL Cetrimida 0,3 g Agar 13,6 pH 7,2 ± 0,2 *Ajustada e/ou suplementada conforme necessário para cumprir os critérios do desempenho PRECAUÇÕES Apenas para uso profissional. AGAR CETRIMIDE Es un medio selectivo utilizado para el aislamiento de Pseudomonas aerug inosa Composición Digerido pancreático de gelatina ,0 g Cloruro de magnesio 1,4 g Sulfato de potasio 10, g Agar 13,6 g Bromuro de Ncetil N,N,N Trimetil amonio ( cetrim ide) 0,3 g Glicerina 10,0 mL Agua destilada 1000 mL pH final 7,2 ± 0,2 Preparación. A cetrimida (brometo de cetiltrimetilamina) é um composto amónio quaternário, que inibe uma vasta variedade de outros organismos, incluindo outras espécies de Pseudomonas e organismos •10 a 99 BAAR em 100 campos = positivo •Média de 1 a 10 BAAR por campo nos primeiros 50 campos = positivo.
Cetrimida Agar Uso Medio utilizado para el aislamiento selectivo de Pseudomonas aeru ginosa y de otras especies del género Su fórmula cumple con los requerimientos de la Armonización de Farmacopeas Europea, Japonesa y de los Estados Unidos de Nor teamérica (EP, JP y USP respectivamente). Agar Cetrimida Cultivo SIN crecimiento Agar Sangre Cultivo con crecimiento Betahemólisis NEGATIVA Agar McConkey Cultivo con crecimiento POSITIVO para BGN No Fermentador PRUEBA DE LA OXIDASA Pruebas Bioquímicas SIMÁcido sulfhídrico NEGATIVO (No hay precipitado negro)Indol NEGATIVO (No hay anillo. Agar, therefore, is a valuable culture medium in the identification of this organism In addition to the promotion of pyocyanin production, Pseudosel Agar also enables the detection of fluorescent products produced by P aeruginosa Cetrimide (Pseudosel) Agar is widely recommended for use in the examination of cosmetics,10 clinical specimens8.
El agar MacConkey es un medio de cultivo selectivo y diferencial para bacterias diseñado para aislar selectivamente bacilos Gram negativos y entéricos (encontrados normalmente en el tracto intestinal) y diferenciarlos sobre la base de la fermentación de la lactosa 1 El cristal violeta y las sales biliares inhiben el crecimiento de organismos grampositivos, lo que permite la selección y. O ágar cetrimida é usado como um meio seletivo para o isolamento de Pseudomonas aeruginosa de espécimes clínicas Composição em g/L Digestão pancreática de gelatina ,00 Sulfato de potássio 10,00. Agar de cetrimida semeado com Pseudomonas aeruginosa Fonte BiotechMichael Domínio público, de Wikimedia Commons O ágar cetrimida é útil no estudo microbiológico de amostras em que se suspeita da presença de Pseudomonas aeruginosaDevese notar que essa bactéria é de extrema importância, porque, embora faça parte da microbiota ambiental normal, ela geralmente se comporta como um.
Cetrimide Agar Página 2 de 1 OPPD63 Versión MDM CIENTÍFICA SAS Calle 7 Sur No 51 A – 90 of 102 Medellín Teléfonos (4) 285 5043 365 9180 81 Cel 311 746 8684, 315 545. Cultivo positivo por Citrobacter Freundii, sensible únicamente a Amikasina Se trató con este antibiótico Falleció a los dos días de haber iniciado los síntomas * Caso No 3 RNT — (AEG), femenino, peso al nacer 3381g, Apgar al 1' — 8 y a los 5' — 9 RPM de 4 horas de evolución Los síntomas se iniciaron a los 4 días. Agar Cetrimide O Agar Cetrimide é um meio de cultura recomendado para o isolamento e identificação das cepas de Pseudomonas Para saber nosso preço de venda para este item é só fazer o orçamento clicando na foto abaixo ou mandar seu orçamento no vendas@prolabcombr.
Cetrimide Agar is used in the isolation and identification of Pseudomonas aeruginosa and is not intended for use in the diagnosis of disease or other conditions in humans Conforms to Harmonized USP/EP/JP Requirements A medium recommended by the Harmonized USP/EP/JP for the isolation and identification of Pseudomonas aeruginosa, in non. AGAR CETRIMIDA Medio sólido Medio de aislamiento Selectivo Las colonias características presentan una pigmentación verde pálido espontánea y fluorescencia verde bajo luz ultravioleta Medio utilizado para el aislamiento selectivo de Pseudomonas aeruginosa y de otras especies del género Pseudomonas. Pseudosel Agar or Cetrimide Agar is used for the selective isolation and presumptive identification of Pseudomonas aeruginosa The medium was first developed by Lowburry and is a modification of Tech Agar (developed by King et al) with addition of 01% cetrimide (cetyl trimethyl ammonium bromide) for the selective inhibition of organisms other than Pseudomonas aeruginosa.
Cetrimida Agar Uso Medio utilizado para el aislamiento selectivo de Pseudomonas aeru ginosa y de otras especies del género Su fórmula cumple con los requerimientos de la Armonización de Farmacopeas Europea, Japonesa y de los Estados Unidos de Nor teamérica (EP, JP y USP respectivamente). Así como para prevenir el crecimiento de los inhibidores de bacterias Gram positivas. Meio de cultura Agar entenda sua função para uso com sangue Publicado em 11/07/18 iStock / Getty Images Plus / Scharvik O ágar sangue é um meio de cultura indicado para o desenvolvimento de fungos, filamentosos e colônias leveduriformes.
Ágar cetrimida fundação, preparação, usos O ágar cetrimida ou cetrimida é um meio de cultura sólido selectivo concebido para o isolamento de Pseudomonas aeruginosa Ele é baseado na demonstração da produção de pigmentos característicos dessa espécie e foi feito a partir da modificação do agar Tech, criado por King, Ward e Raney. Cetrimide agar Pseudomonas selective agar base for microbiology (According harm EP/USP/JP) Find MSDS or SDS, a COA, data sheets and more information. Principio de cetrimida Agar Cetrimida Agar se utiliza como un medio selectivo para el aislamiento de Pseudomonas aeruginosa de pus, esputo y desagües, etc Pseudomonas aeruginosa produce una serie de quelantes de hierro solubles en agua, incluyendo el fluorescente amarilloverde o amarillomarrón pioverdina.
Agar entérico Hektoen (HEK o HE o HEA) es un agar selectivo y diferencial 1 utilizado principalmente para recuperar Salmonella y Shigella HEK contiene indicadores de lactosa fermentación y sulfuro de hidrógeno producción;. Resultados Positivo crecimiento de microorganismos y color azul en el pico alcalinidad Negativo el medio permanece de color verde debido a que no hay desarrollo bacteriano y no hay cambio de color AGAR CETRIMIDA Medio slido Medio de aislamiento Selectivo Medio utilizado para el aislamiento selectivo de Pseudomonas aeruginosa y de otras. 90 –100% de positivo () 75 –,9% de positivo () 10,1 a 25 5 de positivo 0 –10% de positivo O’Haray col ClinMicrobRev Diferenciación entre los géneros Proteus, Providenciay Morganella.
Cetrimide (Pseudosel) Agar is used for the selective isolation and identification of Pseudomonas aeruginosa Cetrimide Agar is widely recommended for use in the examination of cosmetics, clinical specimens for the presence of P aeruginosa, as well as for evaluating the efficacy of disinfectants against this organism. CETRIMIDE AGAR (BASE) PHARMACOPEA MEDIO N Aislamiento selectivo para Pseudomonas aeruginosa en medicamentos (USP) y cosméticos (ISO ) COMPOSICIÓN Peptona pancreátgelatina ,0 g Cetrimida 0,3 g Cloruro magnésico 1,4 g Sulfato Dipotásico 10,0 g Agaragar 13,6 g (Fórmula por litro) pH final 7,2 ± 0,2. Resultados Positivo crecimiento de microorganismos y color azul en el pico alcalinidad Negativo el medio permanece de color verde debido a que no hay desarrollo bacteriano y no hay cambio de color AGAR CETRIMIDA Medio slido Medio de aislamiento Selectivo Medio utilizado para el aislamiento selectivo de Pseudomonas aeruginosa y de otras.
Setirimid agar veya setirimid agar, Pseudomonas aeruginosa'nın izolasyonu için tasarlanmış seçici bir katı kültür ortamıdır Bu türün karakteristik pigmentlerinin üretimini vurgulamaya dayanır ve King, Ward ve Raney tarafından yaratılan Tech agar'ın modifikasyonundan geliştirilmiştir. Cetrimida Agar Base USO Medio utilizado para el aislamiento selectivo de Pseudomonas aeruginosa y de otras especies del género Su fórmula cumple con los requerimientos de la Armonización de Farmacopeas Europea, Japonesa y de los Estados Unidos de Nor teamérica (EP, JP y USP respectivamente) FUNDAMENTO Su formulación permite el crecimiento selectivo de Pseudomonas aeruginosa y estimula la formación de pigmentos. Cetrimide (Pseudosel) Agar is used for the selective isolation and identification of Pseudomonas aeruginosaDehydrated microbiology culture media cultivate and isolate microorganisms for researching purposes Fastdissolving powders come premixed for quick preparation using neutral liquids By standardizing the media employed, the lowdust granule mixtures guarantee that the correct enrichment.
BD Pseudosel Agar Fórmula* por litro de agua purificada Digerido pancreático de gelatina ,0 g Cloruro de magnesio 1,4 Sulfato de potasio 10,0 Glicerol 10,0 ml Cetrimida 0,3 g Agar 13,6 pH 7,2 ± 0,2 *Ajustada y/o suplementada para satisfacer los criterios de rendimiento PRECAUCIONES Solamente para uso profesional. Inocule el microorganismo a identificar en la superficie del agar cetrimida e incube a 37°C durante 14 horas TOLERANCIA A LA CETRIMIDA MEDIO DE CULTIVO Agar cetrimida Peptona de gelatina ,0 g Cloruro de magnesio 1,4 g Sulfato de potasio 10,0 g Bromuro de Ncetil N,N,NTrimetil amonio (cetrimide) 5,0 g Agar 13,6. Agar Cetremide 500 Gr Código 549 Faça uma pergunta sobre este produto Compartilhe Descrição;.
Agar Cetrimida Indique esse produto Variações de Produto Quantidade Agar Cetrimide frasco de 500gr Cod K Solicitar Orçamento Adicione a quantidade Descrição É recomendado pela Farmacopeia Européia para. Cetrimide agar is a type of agar used for the selective isolation of the gramnegative bacterium, Pseudomonas aeruginosa As the name suggests, it contains cetrimide, which is the selective agent against alternate microbial flora Cetrimide also enhances the production of Pseudomonas pigments such as pyocyanin and pyoverdine, which show a characteristic bluegreen and yellowgreen colour. CETRIMIDE AGAR (BASE) PHARMACOPEA MEDIO N Aislamiento selectivo para Pseudomonas aeruginosa en medicamentos (USP) y cosméticos (ISO ) COMPOSICIÓN Peptona pancreátgelatina ,0 g Cetrimida 0,3 g Cloruro magnésico 1,4 g Sulfato Dipotásico 10,0 g Agar agar 13,6 g (Fórmula por litro) pH final 7,2 ± 0,2 PREPARACIÓN.
Preparation of Cetrimide Agar Add 453 gm of the medium in 1 litre of distilled water Add 10ml of glycerol and boil to dissolve completely Sterilize by autoclaving at 121°C for 15 minutes Cool the medium to approximately 50°C and pour into sterile Petri dishes Interpretation of Results on Cetrimide Agar. Cetrimide Agar Página 1 de 1 OPPD63 Versión MDM CIENTÍFICA SAS Calle 7 Sur No 51 A – 90 of 102 Medellín Teléfonos (4) 285 5043 365 9180 81 Cel 311 746 8684, 315 545. Agar levine emb es un medio selectivo diferencial, adecuado para el crecimiento de enterobacterias, que inhibe el crecimiento de bacterias gram positivas.
Cetrimide agar Pseudomonas selective agar base for microbiology (According harm EP/USP/JP) Find MSDS or SDS, a COA, data sheets and more information. Cetrimida Agar Base, para el aislamiento selectivo de Pseudomonas aeruginosa a partir de muestras clínicas Ver ficha técnica * Aplica para Colombia Caja Limpiar Cetrimide Agar Base (Agar Base Cetrimida) 500 g HiMEDIA M024 cantidad Añadir al carrito SKU Categoría. Columbia agar Base suplementado con 5% de sangre ovina de color verdoso) por el peróxido de hidrógeno generado por los microorganismos Hemólisis bet a lisis total de los glóbulos rojos Se observa un halo claro, brillante alrededor de la colonia en estudio.
Se realizaron cultivos en agar cetrimida ( medio selectivo) de los alimentos pepino, rábano, guayaba, papaya, queso, ejotes, lechuga y chayote, para poder identificar a las bacteria de género Pseudomonas FIGURA 1 Cultivos en placas de agar cetrimida con crecimiento positivo de los aislados de chayote, rábano, pepino y papaya. Pseudomonas aeruginosa, según Norma UNE , es toda colonia verde, azul, amarilla, fluorescente o rojamarrón procedente de Cetrimida CN Agar, que resulta oxidasa positiva (viraje a azul oscuro), Acetamida positiva (viraje a amarillo rojo tras añadir reactivo Nessler) y King B positivo (fluorescente) en menos de días. Agar cetrimida Agar citrato de Simmons Agar DNA azultoluidina En caso positivo se presenta para los dos primeros métodos después de algunos minutos, un viraje a rojo Con el reactivo de.
Izvorna formula sadrži soli magnezijevog klorida, kalij sulfat, digestiju želatine pankreasa i agaragar Modifikacija formule sastojala se od dodavanja cetrimida (cetil trimetil amonij bromida) i glicerola Cetrimidni agar je koristan za mikrobiološka ispitivanja uzoraka na kojima je prisutna Pseudomonas aeruginosa. RESUMEN Se realizó un compendio con más de 30 publicaciones que abordan las nuevas investigaciones sobre los principales elementos que intervienen en el mecanismo de infección y los métodos diagnósticos más utilizados para la detección del Staphylococcus aureus por parte de los laboratorios microbiológicos en el mundo y Cuba Nuevas moléculas que contribuyeron al proceso infectivo. Algunas cepas pueden crecer en Agar Cetrimida sin fluorescencia y en Agar CN Muchas cepas no crecen a más de 35°C En TSA algunas cepas crecen con colonias regulares, redondeadas, blanquecinas, crema o amarillas.
Cetrimide or Cetrimide Agar is a selective solid culture medium designed for the isolation of Pseudomonas aeruginosa It is based on showing the production of characteristic pigments of this species and was made from the modification of Tech agar, created by King, Ward and Raney. Características Pseudomonas spp su morfología colonial es característica de identificación en algunos medios de cultivo, por ejemplo en medio agar Cetrimida, es un bacilo curvo o recto, aislado o en pareja o cadenas cortas, Gram negativa () esta bacteria tiene motilidad positiva gracias a su flagelo (solo cuenta con uno) Tiene la capacidad de formar biofilm, tiene un ligero aroma a. Agar Cetrimida Indique esse produto Variações de Produto Quantidade Agar Cetrimide frasco de 500gr Cod K Solicitar Orçamento Adicione a quantidade Descrição É recomendado pela Farmacopeia Européia para.
Cetrimide agar is used to determine the ability of an organism to grow in the presence of cetrimide, a toxic substance that inhibits the growth of many bacteria by causing the release of nitrogen and phosphorous, which slows or kills the organisms because organisms other than P aeruginosa are unable to withstand this germicidal activity, while P aeruginosa is resistant to cetrimide. Agar BHI con 5% sangre de oveja El agar infusión cerebrocorazón con 510% de sangre de oveja adicionado de cloranfenicol y gentamicina inhibe el crecimiento de bacterias, pero permite el crecimiento de hongos, incluso de los más exigentes Este agar. Positivo Inóculos destes tubos positivos foram transferidos para o meio caldo acetamida a fim de serem confirmados Das amostras confirmadas, fezse semeio em ágar leite e ágar cetrimida para descartar possíveis microrganismos que não o pesquisado O caldo dextrose azida (CDA), um ótimo inibidor de Gram negativos e o ágar seletivo para.
TABLA DE CONTENIDO 1 Objetivo 2 Introducci贸n 3 Bioseguridad 4 Control de calidad 5 Agar Nutritivo 6 Agar Sangre 7 Agar Mc Conkey 8 Agar Muller Hinton 9. Agar Cetrimidu alebo agar cetrimidu je selektívne pevné kultivačné médium určené na izoláciu Pseudomonas aeruginosa Je založený na zvýraznení produkcie pigmentov charakteristických pre tento druh a bol vyvinutý z modifikácie Tech agaru, vytvoreného Kingom, Wardom a Raneym. Cetrimida agar Foundation, การเตรียม, การใช้ประโยชน์ เจทริติเจล หรือเซทริไมด์เป็นสื่อวัฒนธรรมที่เป็นของแข็งซึ่งคัดเลือกมาเพื่อการแยก Pseudomonas.
De P aeruginosa y agar cetrimida, como prueba confirmativa, además de las pruebas de oxidasa y catalasa, en este trabajo se muestran resultados obtenidos en la identificación de P aeruginosa en 69 muestras de agua de cisterna, pozo, presa y residual doméstico Resultados Del total de muestras analizadas, resultaron positivas a P.
Feriadelasciencias Unam Mx Anteriores Feria21 Feria012 01 Identificacion De Pseudomona Aeruginosa Por Reacci Pdf
Http Catarina Udlap Mx U Dl A Tales Documentos Lbc Gonzalez Pena Ma Capitulo5 Pdf

Agar Cetrimide Frasco Kasvi Melhor Preco Na Forlabexpress
Microbiologia Ifrj Campus Rio De Janeiro Quatro Bacterias Em Cinco Meios Distintos G4

Tipos De Agar Nuritivos Diferenciales Y No Diferenciales Docsity
Http Kemitekskimya Com Tr Files c Pdf
Www Com Resource Aspx Idx 59
Jornades Uab Cat Workshopmrama Sites Jornades Uab Cat Workshopmrama Files Medios Cromogenicos Laboratorios Microkit Pdf
2

Informacion Y Novedades Sobre Medios De Cultivo
Http Sisbib Unmsm Edu Pe Bvrevistas Epidemiologia V16 N2 Pdf A11v16n2 Pdf

Medios De Cultivo Agar Mossel Sangre Emb Barid Parker Cetrimida Chocolate Studocu

Atena Iberica Probiotic Health Care Uso Profesional

Sangre Agar Base Columbia
Http Kemitekskimya Com Tr Files d Pdf

Medios De Cultivo Microbiologia Para Humanos

Identification Scheme Used During The Study Download Scientific Diagram

Cetrimide Agar
Www Com Resource Aspx Idx 8794

Medios De Cultivos Selectivos Fundamento Solidos Y Liquidos

Pseudomonas Aeruginosa Nelle Acque Laboratorio Scolastico

Controle De Qualidade Em Industria Cetrimide Agar

Somos Su Proveedor De Medios De Cultivo Para Laboratorio En Medellin

Burkholderia Cepacia pt Agar Base

Tipos De Agar Nuritivos Diferenciales Y No Diferenciales Docsity
Gale Onefile Informe Academico Document Evaluacion De Una Formulacion Para La Conservacion De Cepas De Pseudomona Aeruginosa
Www Seimc Org Contenidos Documentoscientificos Procedimientosmicrobiologia Seimc Procedimientomicrobiologia28 Pdf
Http Sedici Unlp Edu Ar Bitstream Handle Documento Completo Pdf Pdfa Pdf Sequence 1 Isallowed Y

Bio Bacter Quios
Http Www Red Gdl Com Wp Content Uploads 14 06 Catalogo Bioxon Pdf
Http Mdmcientifica Com Wp Content Uploads 16 12 Cetrimide Medio Agar Mdm Cient C3 Adfica Inserto O P Pd 63 Pdf

Pseudomonas Aeruginosa P Putida P Fluorescens Morfologia Medios De Cultivo Enfermedades Y Mas Microbitos Blog

M Ident Pseudomonas Aeruginosa

Cromokit Burkholderia Agar
Www Merckmillipore Com Intershop Web Wfs Merck Br Site Pt Br Brl Showdocument File Productsku Mda Chem Documentid 0811 069 Pronet Documenttype Pi Language Es Country Nf Origin Pdp
Www Redalyc Org Pdf 31 Pdf

Metodos Oficiales De Analisis Aguas By Laboratorio De Microbioloxia E Biotecnoloxia Issuu

Agar Base Cetrimide Frasco Com 500 Gramas Mod M024 500g Himedia Dsyslab Produtos Para Laboratorios Clinicas E Hospitais

Pseudomonas Aeruginosa Principal Responsable De La Retirada De Cosmeticos

Microbiologiaindustrial Instagram Posts Gramho Com

Agar Cetrimida Fundamento Preparacion Usos
Http Www Digemid Minsa Gob Pe Upload Uploaded Pdf Establecimientos Reuniones Reunion Ii Ii Ensayos Microbiol C3 gicos En Control De Calidad Pdf

Atena Iberica Probiotic Health Care Uso Profesional

Placa De Agar Wikipedia La Enciclopedia Libre
Www Studocu Com Es Ar Document Universidad Nacional De Quilmes Microbiologia General Resumenes Medios De Cultivo Agar Mossel Sangre Emb Barid Parker Cetrimida Chocolate View

Eosina Metileno Azul Medio De Crecimiento Microbiologia Agar Bacterias Gramnegativas Rta In Vitro Azul De Metileno Png Klipartz

Aislamiento De Especies De Pseudomonas De Las Lineas De Agua De Las Unidades Odontologicas

Pseudomonas

Atena Iberica Probiotic Health Care Uso Profesional
Http Www Probac Com Br Anexos Bulas Seletivos Meios seletivos gram positivos e gram negativos rev 05 Pdf

Aislamiento De Especies De Pseudomonas De Las Lineas De Agua De Las Unidades Odontologicas
Www Ridaa Unicen Edu Ar Xmlui Bitstream Handle 1157 C3 81lvarez 2c guevara julieta Pdf Sequence 1 Isallowed Y
Http Www Bvv Sld Cu Vaccimonitor Vm04 Pdf
Http Vinculacion Dgire Unam Mx Vinculacion 1 Memoria Congreso 17 Trabajos Ciencias Biologicas Biologia 6 Pdf
Http Www Bvv Sld Cu Vaccimonitor Vm04 Pdf

Medios De Cultivo En Un Laboratorio De Microbiologc3ada

Cetrimide Agar Base

Agar Cetrimida Fundamento Preparacion Usos

Pin En Bacterias

Pseudomonas Aeruginosa En Una Muestra De Agua Institut Merce Rodoreda

Deteccion Pseudomonas Aureginosa Agua Pseudomonas Agua

Cetrimida Agar Base

Ficokit Cianokit Mycokit
Http Catarina Udlap Mx U Dl A Tales Documentos Lbc Gonzalez Pena Ma Capitulo5 Pdf

Medios De Cultivo
Www Microkit Es Pdf Catalogo14 Pdf

Manual Preparacion De Medios De Cultivo By Sandralucia 71 Issuu

Aeruginosa P Putida P Fluorescens Morfologia
Http Sedici Unlp Edu Ar Bitstream Handle Documento Completo Pdf Pdfa Pdf Sequence 1 Isallowed Y

Micro Informe 2 1

Aislamiento De Especies De Pseudomonas De Las Lineas De Agua De Las Unidades Odontologicas

Cetrimide Agar Es Un Medio Selectivo Y Molecular Biotecnologia Mich Facebook
Http Www Bvv Sld Cu Vaccimonitor Vm04 Pdf

10 Ideas De Pruebas De Identificacion Prueba Bacteriologia Microbiologia

Placa De Agar Wikiwand

Agar Cetrimida Wikipedia

Placa De Agar Wikiwand

Cromokit Burkholderia Agar

Oxidasepositive Instagram Posts Photos And Videos Picuki Com

Fotos De Pseudomonas Aeruginosa Banco De Fotos E Imagenes De Stock Istock

Analisis Fisico Quimico Y Bacteriologico De Aguas El Sindical

Pseudomona Aeruginosa By Johanna Gutierrez

Pseudomona Aeruginosa

Biotecnologia Para Descontaminacion Una Bacteria Que Transforma Suelos

Aislamiento De Especies De Pseudomonas De Las Lineas De Agua De Las Unidades Odontologicas

Placa Agar Vogel Cetrimide Macconkey 90mm Plastlabor
Www Seimc Org Contenidos Documentoscientificos Procedimientosmicrobiologia Seimc Procedimientomicrobiologia28 Pdf

Analista Microbiologico Pseudomonas Salmonella Y Listeria Apuntes De Microbiologia Docsity
Mueller Hinton Agar Wikipedia

Macconkey Instagram Posts Gramho Com

Efectividad De La Asociacion Cetrimida Clorhexidina 15 0 15 Frente A Clorhexidina 2 En La Erradicacion De Biofilms De Enterococcus Faecalis

Agar Cetrimida Agar King Microbiologia Bienestar

Agar Macconkey Medio De Cultivo Solido Ppt Video Online Descargar

Examen De Practicas De Microbiologia Ex Men De Pr Cticas Se Pueden Recontar Todo Tipo De Microorganismos En La Prueba De Hem Lisis Las Colonias Presentan Studocu



